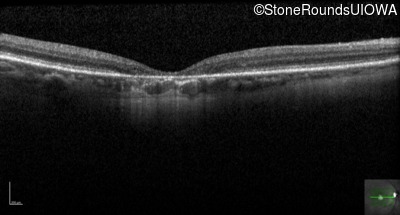
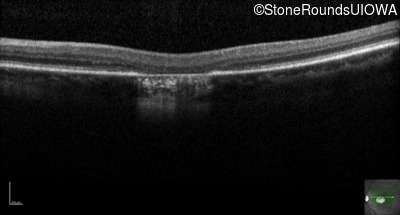

Case
SR48
Student Mode
AD Cone and Cone Rod Dystrophy (IA1bii)
Female
Female
Hidden
SR48
Student Mode
AD Cone and Cone Rod Dystrophy (IA1bii)
Female
Female
History
This 59 year old woman first noticed a reduction in her visual acuity and photophobia in her late teens.
Diagnosis & molecular findings
| Disease | Gene | Allele 1 variant(s) | Allele 2 variant(s) | Inheritance mode |
|---|---|---|---|---|
| AD Cone and Cone Rod Dystrophy | GUCA1A | Glu155Gly GAG>GGG | AD |
Disease:
Gene:
Allele 1:
Glu155Gly GAG>GGG
Allele 2:
Inheritance:
AD